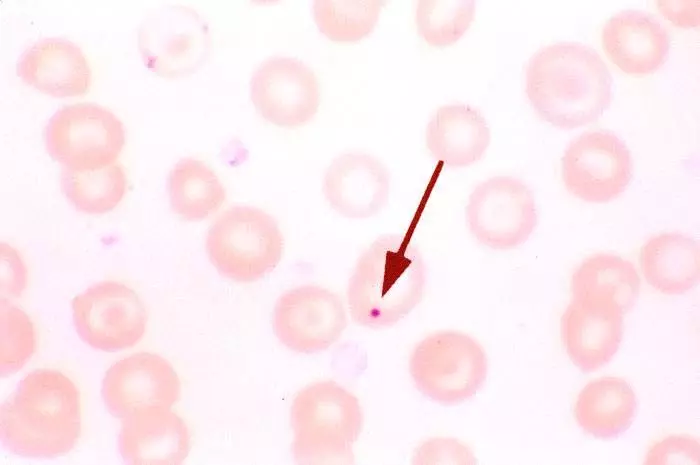
Howell Jolly Bodies Blood Film SimpleMed

By Dr. Keertana Anne and Dr. Tom Bradley
Next Lesson - Full Blood Count
Abstract
- Haematopoiesis (also known as haemopoiesis) is the production of blood cells. It occurs in bone marrow and begins from haematopoietic stem cells.
- There are multiple types of blood cells with various functions, from erythrocytes (red blood cells) which transport oxygen around the body to leukocytes (white blood cells) which fight off infections.
- The spleen is a highly vascular organ with many functions including: phagocytosis, extra-medullary haematopoiesis and immune functions.
- Splenomegaly is when the spleen becomes enlarged. This can be due to various pathologies.
- Hyposplenism is a lack of functioning splenic tissue.
Core
Haematopoiesis is the production of mature blood cells (red blood cells (RBCs), platelets and the majority of white blood cells (WBCs)) from stem cells occurring in the bone marrow. In infants, it takes place throughout the skeleton, while in adults there is a more limited distribution namely the axial skeleton (bones of the skull and trunk) including the pelvis, sternum, skull, ribs and vertebrae.
This process begins from a single cell type - the multipotent haematopoietic stem cell (HPSC)(sometimes called a haemocytoblast). Production of certain cell types is regulated by various hormones.
- RBC production is stimulated by Erythropoietin (EPO).
- Platelet production is stimulated by Thrombopoietin.
- Granulocytes (certain WBCs namely neutrophils, basophils, eosinophils) production is stimulated by G-CSF.
- Lymphocyte production is stimulated by Interleukins and TNF-α
The HPSCs differentiate into either common myeloid progenitor cells or common lymphoid progenitor cells, and from them all the other blood cells develop.

Diagram - Lineage of the Multipotent Haematopoietic Stem Cell
SimpleMed original by Dr. Keertana Anne
Erythropoiesis is the continuous process of erythrocyte production. Erythrocytes or red blood cells transport oxygen around the body.
Erythrocytes classically have a biconcave structure with a diameter of 8µm. Their small size coupled with their shape helps them to squeeze through the small lumen of capillaries. Erythrocytes are enucleated cells (without a nucleus), which allows more space for haemoglobin to be contained within each erythrocyte (the majority of the cell volume is taken up by haemoglobin).
See our article on biological membranes for more information on the structure of the erythrocyte cell membrane and the various diseases that can result from alterations in membrane structure.
Haemoglobin is a globular protein with a tetramer structure of two pairs of globin chains - in an α2β2 structure. Each chain has its own essential prosthetic haem group (a protoporphyrin ring and an iron atom). One molecule of O2 binds to the haem group and causes movement of the iron into the plane of the ring, and a conformational change in the structure.
Deoxyhaemoglobin exists in low affinity (T - tense) state or high affinity (R - relaxed) state. When oxygen binds to haemoglobin, it converts from the T state to the R state, allowing oxygen to bind much more easily - this especially favours oxygen loading in the lungs where there is a very high pO2, and the release of oxygen at the tissues where there is a very low pO2. Each haemoglobin molecule can bind 4 O2 molecules.
Each red blood cell has a lifespan of 120 days therefore frequent erythropoiesis is required to replenish the supply of RBCs in the blood.
RBCs cannot undergo mitosis due to their lack of a nucleus; the process of erythropoiesis is as follows:
- Red blood cells are originally derived from common myeloid progenitor (CMP) cells which are committed to the path of erythropoiesis by transcription factors.
- Activation of transcription factors drives differentiation from CMP cells through a series of erythroid precursor stages, eventually forming reticulocytes. During this process the nucleus and most organelles are extruded. The hormone erythropoietin (EPO) is essential for survival and maturation of these erythroid precursors.
- Once reticulocytes are in the bloodstream, they mature over two days into erythrocytes by removing the rest of the remaining organelles.
The amount of production of erythrocytes can vary. More erythrocytes can be formed, in response to a shortage of oxygen in the blood. This response is driven by increased levels of EPO and is as follows:
- Interstitial peritubular cells in the kidney detect hypoxia (reduced oxygen supply to the tissues). Chronic hypoxia can generally be due to: decreased oxygen carrying capacity in the blood (anaemic hypoxia) or decreased availability of O2 in the environment (hypoxaemic hypoxia).
- Increased production of EPO in the kidney (and liver to smaller extent).
- EPO stimulates maturation and release of red cells from the bone marrow, mainly by promoting survival and differentiation of erythroid progenitor cells.
- Number of red cells and haemoglobin increases allowing more O2 to be delivered to tissues relieving the hypoxia.
B and T lymphocytes are cells of the lymphatic system (even though they can be found in the bloodstream).
B lymphocytes are a type of WBC that assist in the adaptive immune response of the body. They are able to recognise non-self-antigens and produce a large number of antigen specific antibodies. The development of B lymphocytes begins in the fetal bone marrow and liver. These then continue to mature in the bone marrow (unlike T-cells), where they remain until they are required during an immune response.
T lymphocytes are another type of WBC that have a key role in the body’s immune response. These also arise from the bone marrow but migrate to the thymus gland, where they develop and mature.
For a more detailed explanation of the action of lymphocytes, take a look at our article on adaptive immunity.
This is the process of platelet (or thrombocyte) formation. Platelets are key in the process of blood clotting. Platelets form by budding off from the membrane of megakaryocytes (derived from CMP cells). This is driven by the hormone thrombopoietin (TPO).
Monocytes are phagocytic cells which circulate in the blood. They are derived from the myeloblast, which in turn is derived from common myeloid progenitor. Blood monocytes leave the blood circulation after 20 hours and become known as tissue macrophages, which have a phagocytic action.
The granulocytes are a family of white blood cells made up of basophils, neutrophils and eosinophils. Granulocytes are all white blood cells involved in microbial clearance. They all have large quantities of cytoplasmic granules within the cells, each containing inflammatory markers. These cells have the same pathway of formation as the monocytes; common myeloid progenitor followed by myeloblasts.
- Neutrophils phagocytose and destroy any foreign organisms by releasing reactive oxygen species.
- Eosinophils are effector cells, which have actions against parasitic infections and are involved in many different immune responses. Pathologically, they take part in the process of allergic reactions.
- Basophils are circulating leucocytes that contain histamine, which they release as part of the immune response.
The spleen is one of the main organs in the reticuloendothelial system (RES). The spleen’s function is to identify and act against foreign pathogens (using phagocytic cells). Blood is filtered as it passes through the spleen by the reticuloendothelial (RE) cells.
The spleen consists of red pulp which removes old red blood cells and metabolises haemoglobin; and white pulp which forms antibodies (formed of lymphoid tissue) and removes any bacteria or erythrocytes coated in antibodies. The spleen is particularly effective against encapsulated bacteria. White cells and plasma preferentially pass through the white pulp and red blood cells pass through the red pulp.
Another function of the spleen is limited blood pooling. Platelets and some red cells can be stored within the spleen and released into the circulation, although this has a relatively small role in humans during bleeding.
Splenomegaly - Enlargement of the Spleen
This process usually occurs when the spleen has an increased workload (e.g. overworking red or white pulp). Other causes include:
- Back pressure due to portal hypertension.
- Infiltration by foreign cells - malignant cells in the blood (e.g. leukaemia) and other cancer metastases; infectious diseases (e.g. malaria, schistosomiasis and HIV).
- Accumulation of waste products of metabolism.
A healthy spleen should not be palpable as it will lie under the ribs. An enlarged spleen is palpable usually in the left hypochondrium, and it will no longer be protected by the ribs. Therefore, the risk of rupture is increased. Splenic rupture is life threatening as it will cause a large amount of internal bleeding due to the spleen's rich blood supply. If untreated this can cause haemodynamic shock and death. Patients with splenomegaly are encouraged to avoid activities (such as contact sport) that may cause splenic rupture.
Hyposplenism - Reduction in the Function of the Spleen
There are multiple causes of hyposplenism including:
- Splenectomy (surgical removal of the spleen) - this may be required due to splenic rupture from trauma; cancer or to treat diseases such a hereditary spherocytosis or ITP.
- Diseases that destroy splenic tissue (e.g. sickle cell disease and coeliac disease).
Hyposplenic or asplenic patients have an increased risk of developing sepsis, especially from encapsulated organisms (Neisseria meningitidis, Streptococcus pneumoniae & Haemophilus influenzae). This is as the white pulp is no longer present to remove the encapsulated bacteria allowing them to proliferate in the blood and manifest as sepsis. Hyposplenic patients therefore are usually given various vaccinations, prophylactic antibiotics and should carry a card notifying medical staff of their condition.
A typical blood film for hyposplenic patients will contain RBCs with Howell-Jolly bodies (remnants of DNA still in the cytoplasm). This is indicative of damage to the spleen, as a normally functioning spleen would remove these defective cells as they pass through it.
Image - A Red Blood Cell film showing a Howell-Jolly Body
Creative commons source Isis325 [CC BY-SA 2.0 (https://creativecommons.org/licenses/by-sa/2.0)]
Edited by: Dr. Ben Appleby
Reviewed by: Dr. Marcus Judge
- 12485

